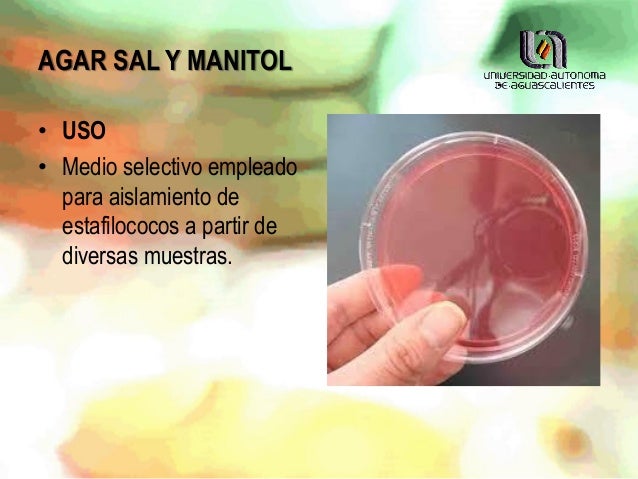
Medio De Cultivo Agar Sal Y Manitol www.slideshare.net

Medio De Cultivo Agar Sal Y Manitol

El agar sal y manitol es un medio de cultivo diferencial y selectivo usado en microbiología. Se emplea para aislar e identificar microorganismos, especialmente el Staphylococcus aureus.
Preparación del Medio de Cultivo Agar Sal y Manitol: Paso a Paso
A continuación, te explico cómo preparar este medio en el laboratorio. Cada paso es importante para un resultado exitoso. Recuerda seguir las instrucciones cuidadosamente.
Paso 1: Reúne los Materiales Necesarios
Primero, debes tener todos los ingredientes. Necesitarás: Extracto de carne, Peptona, Cloruro de sodio (Sal), Manitol, Rojo fenol (indicador de pH), Agar y Agua destilada o desionizada.
Además, necesitarás material de laboratorio. Esto incluye: Balanza analítica, Matraz Erlenmeyer, Probeta graduada, Agitador magnético (opcional), Placas de Petri estériles, Autoclave y Mechero Bunsen.
Paso 2: Calcula las Cantidades
Consulta la etiqueta del fabricante para saber las cantidades exactas. Generalmente, las cantidades para 1 litro de medio son las siguientes. Extracto de carne: 1.0 g, Peptona: 10.0 g, Cloruro de sodio (NaCl): 75.0 g, Manitol: 10.0 g, Rojo fenol: 0.025 g y Agar: 15.0 g. Ajusta las cantidades si vas a preparar un volumen diferente.
Por ejemplo, si quieres preparar solo 500 ml, divide todas las cantidades por dos. Esto te daría: Extracto de carne: 0.5 g, Peptona: 5.0 g, Cloruro de sodio (NaCl): 37.5 g, Manitol: 5.0 g, Rojo fenol: 0.0125 g y Agar: 7.5 g.
Paso 3: Pesa los Ingredientes
Utiliza la balanza analítica para pesar cada ingrediente. Asegúrate de usar un recipiente limpio y seco para cada uno. Registra el peso exacto de cada sustancia.
Por ejemplo, pesa los 75 gramos de cloruro de sodio. Luego, pesa los 10 gramos de manitol. Haz esto para cada ingrediente.
Paso 4: Disuelve los Ingredientes
Vierte el agua destilada en el matraz Erlenmeyer. Agrega los ingredientes pesados al agua. Agita suavemente para disolverlos.
Puedes usar un agitador magnético para facilitar la disolución. Calienta ligeramente la solución si es necesario, pero evita que hierva.
Paso 5: Ajusta el pH
Mide el pH de la solución. El pH final debe estar alrededor de 7.4. Usa una solución de NaOH (hidróxido de sodio) o HCl (ácido clorhídrico) para ajustarlo si es necesario.
Añade la solución de NaOH o HCl gota a gota. Mide el pH después de cada adición hasta alcanzar el valor deseado. Es importante ser preciso.
Paso 6: Esteriliza en Autoclave
Esteriliza el medio de cultivo en autoclave. La temperatura y el tiempo típicos son 121 °C durante 15 minutos.
Asegúrate de que el matraz Erlenmeyer esté tapado correctamente. Sigue las instrucciones del fabricante de la autoclave.
Paso 7: Vierte en Placas de Petri
Una vez que el medio se enfríe un poco (pero aún esté líquido), viértelo en las placas de Petri estériles. Trabaja cerca de un mechero Bunsen para mantener la esterilidad.
Llena cada placa hasta aproximadamente la mitad. Deja que el agar se solidifique completamente. Esto toma alrededor de 30 minutos.
Paso 8: Almacena las Placas
Guarda las placas de agar sal y manitol en el refrigerador (4 °C). Protégelas de la luz para evitar su deterioro.
Las placas pueden almacenarse durante varias semanas. Verifica que no haya contaminación antes de usarlas.
Paso 9: Control de Calidad
Realiza un control de calidad. Inocula algunas placas con Staphylococcus aureus y Staphylococcus epidermidis. Observa el crecimiento y el cambio de color del indicador de pH.
Si el Staphylococcus aureus fermenta el manitol, el medio se tornará amarillo. El Staphylococcus epidermidis no fermenta el manitol y no cambiará el color del medio.
Recuerda que la práctica y la precisión son claves para obtener buenos resultados. ¡Mucha suerte!